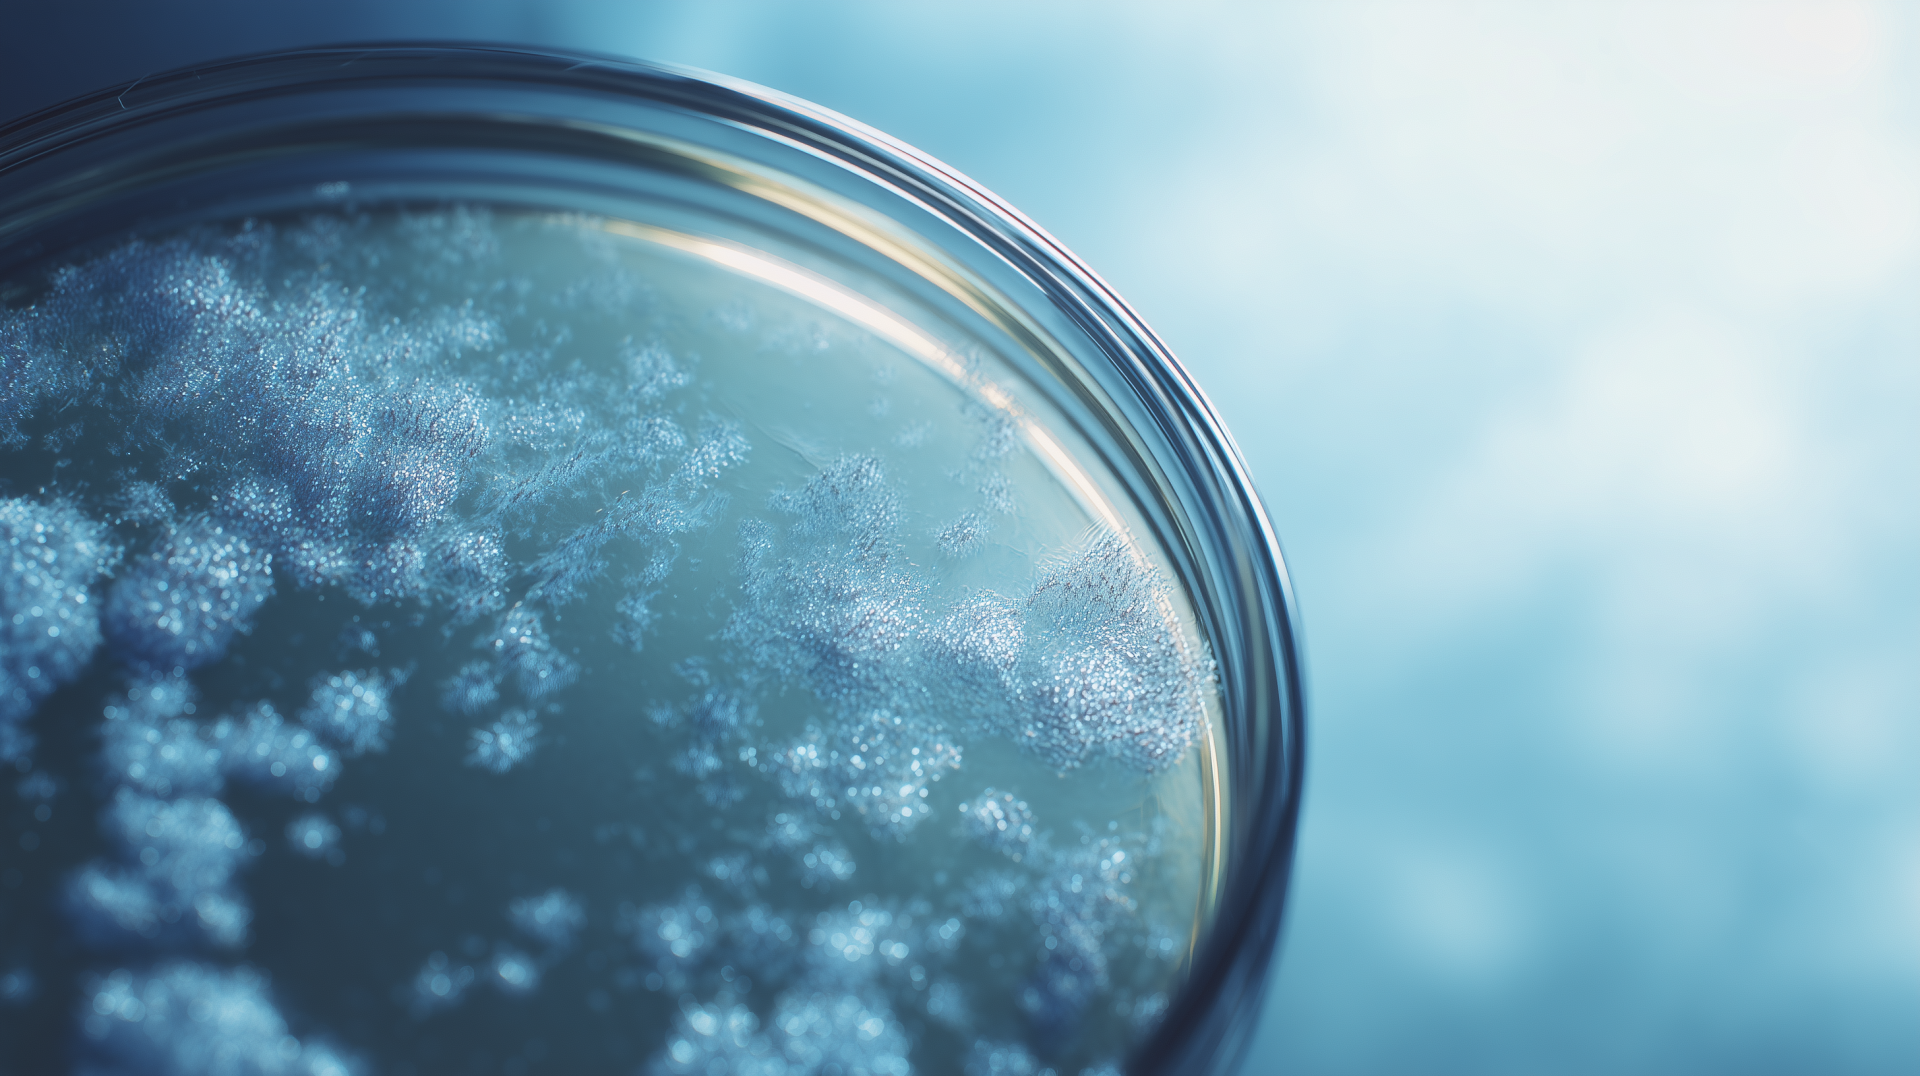
260120_CERTANIA_GroupeIcare_AI_PetriDishBacteria

Get in touch with us
ICARE Laboratory Head Office
6 rue Emile DUCLAUX
Biopôle Clermont-Limagne
63 360 Saint-Beauzire
France
Phone: +33 473 339999
E-mail: communication@groupeicare.com
Since 1995, we have focussed on reliably ensuring the quality and regulatory safety of medical and pharmaceutical products. Our multidisciplinary teams combine microbiological and physico-chemical tests, biocompatibility and toxicology tests, sterility and endotoxin tests as well as the validation of processes, devices and cleanrooms – all under one roof.
With this comprehensive laboratory and consulting expertise, we support manufacturers in developing products in compliance with regulations, recognising risks at an early stage and implementing robust market approval strategies. Our experts support projects from methodological development and documentation through to regulatory submission and are also on hand to help with contamination problems or risk analyses.
Over 500 international customers – from start-ups to global manufacturers – rely on our practical solutions, technical precision and outstanding quality standards. With locations in France, Switzerland and Brazil and a team that is actively involved in standardisation and regulatory processes, we offer global performance with in-depth expertise. In this way, we ensure the conformity of sensitive products and create a solid basis for successful approvals.
ICARE Laboratory Head Office
6 rue Emile DUCLAUX
Biopôle Clermont-Limagne
63 360 Saint-Beauzire
France
Phone: +33 473 339999
E-mail: communication@groupeicare.com